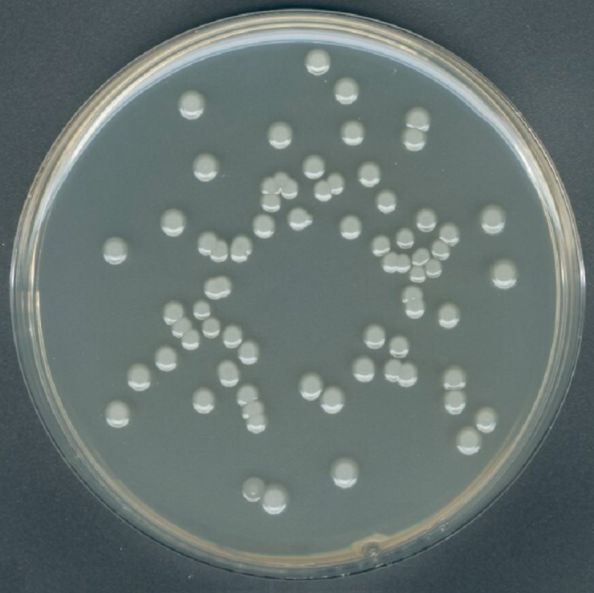
产品封面图

万千商家帮你免费找货
0 人在求购买到急需产品
- 详细信息
- 文献和实验
- 技术资料
- 库存:
100
- 英文名:
Korser Citrate Sodium Broth
- 保质期:
3年
- 供应商:
优利科(上海)生命科学有限公司
- 保存条件:
常温
- 规格:
详询
| 产品名 | Korser氏枸椽酸盐肉汤 |
| 英文名 | Korser Citrate Sodium Broth |
| 规格 | 250g |
| 用途 | 用于大肠菌群的确诊试验(APHA) |
操作步骤
1、按国家标准、SN标准、FDA标准或其它方法制备样品液;
2、取样品液 1ml 加入冷却至 45-50℃ 显色培养基中混匀或涂布于平板上;
3、36℃培养 18~24h,选用有 30~200 个菌落的平板,计数平板上出现的典型大肠菌群和大肠杆菌菌落。大肠杆菌典型菌落为蓝色至紫色,大肠菌群为粉红色菌落,其它细菌为无色或黄色菌落 ;总大肠菌群=蓝色菌落+紫色菌落+粉红色菌落 大肠杆菌=蓝色菌落+紫色菌落;
4、对可疑大肠杆菌菌落可划线接种到营养琼脂平板上,36℃ 培养 12-16 小时,挑取单菌落做大肠杆菌全套生化试验(本公司有生化鉴定管套装 4种x4套)。
贮存
制备好的平板应立即使用,应避免光线直接照射。干燥培养基应放置于阴暗干燥处, 保存温度 2-8℃,注意避光保存。
失效
干燥培养基超过保质期、结块和颜色变化都不能使用。
注意
此培养基仅供实验室使用。

*请佩戴口罩操作,以避免因培养基粉尘而引起呼吸道系统不适。
*干粉培养基容易吸潮结块,使用后应立即旋紧瓶盖。
*平板厚度过薄容易造成琼脂水分保持性下降,开裂,自制平板时需注意培养基的厚度;15-20mL(Φ90mm)体积培养基,平板培养基厚度至少为2mm。
储存条件及保质期→脱水干粉培养基的贮存期一般为二年,需贮存于避光和阴凉干燥的环境之下,使用后请立即旋紧瓶盖。
废物处置→检测之后带菌平板置于121℃下高压灭菌30分钟。

Korser氏枸椽酸盐肉汤我司优势:
1.现货直销,供应周期短(除了缺货需要仓库供货之外),快递送货上门;
2.我司提供的产品都是经正规渠道获取,除了代理国际知名品牌,还注重自主研发,保质保量,能保证客户的科研实验顺利进行;
3.我司提供的产品均为科研用的产品,不做临床诊断;
4.我司拥有多年的市场销售经验,同时也具备雄厚的技术背景,拥有一批专业的技术人员,能为广大客户提供相应的技术支持和服务;
5.价格实惠,订购量越大优惠越多,欢迎来电获取实时报价。
| GAM 半固体培养基GAM 半流動培地GAM Semisolid Medium |
| GAM 半固体培养基(不含葡萄糖)GAM Semisolid without Dextrose |
| GAM 琼脂GAM 寒天GAM Agar |
| 改良 GAM 肉汤基础変法 GAM ブイヨン基礎GAM Broth Base,Modified |
| 改良 GAM 琼脂基础変法 GAM 寒天基礎GAM Agar Base,Modified |
| BDS 培养基BDS 培地BDS Medium |
| 拟杆菌胆汁七叶苷琼脂基础(BBE)BBE 寒天基礎Bacteroides Bile Esculin Agar Base |
| 肉浸液肉汤肉エキスブイヨンMeat Infusion Broth |
| 甘露醇卵黄多粘菌素琼脂基础(MYP) MYP 寒天基礎Mannitol-Egg-Yolk-Polymyxin agar Base |
| 酪蛋白琼脂カゼイン寒天Casein Agar |
风险提示:丁香通仅作为第三方平台,为商家信息发布提供平台空间。用户咨询产品时请注意保护个人信息及财产安全,合理判断,谨慎选购商品,商家和用户对交易行为负责。对于医疗器械类产品,请先查证核实企业经营资质和医疗器械产品注册证情况。
文献和实验过滤。在每1000mL肉汤内,再加葡萄糖10g。然后装瓶,每瓶500mL。放置高压灭菌器内经121℃灭菌15min,备用。 注:蛋白胨液的制备:取新鲜猪胃,去脂绞碎。称取350g加50℃左右蒸馏水1000mL,充分摇匀。 再加盐酸(化学纯,比重1.19)10mL,经充分混合后,置56℃温箱中消化24h(每小时搅拌1~2次),消化完毕后,加热,用滤纸过滤,备用。
成分 水解酪蛋白 20g 酵母浸膏粉 10g 氯化钠 2.5g 磷酸氢二钠 15g 葡萄糖 5g 微量元素 0.5mL 蒸馏水 1000mL pH7.5 制法 溶解后校正pH,高压灭菌121℃ 15min,待冷至45~50℃时,加入林可霉素溶液,每毫升培养基内 含90μg。 微量元素配方 硫酸镁 5g,氯化铁 0.5g,氯化钻
培养基、Korser氏枸掾酸盐肉汤、结晶紫中性红胆盐琼脂(VRBA)、Butterfield氏磷酸盐缓冲稀释液、生理盐水、革兰氏染色液、Kovacs氏靛基质试剂、甲基红指示剂、Voges-proskauer(V-P)试剂、 4 样品制备 4.1 以无菌操作取有代表性的样品盛于灭菌容器内。如有包装,则用75%乙醇在包装开口处擦拭后取样。 4.2 制备样品匀液 以无菌操作取25g样品,放入装有225ml稀释剂的灭菌均质杯内,于8000r/min均质1-2
技术资料